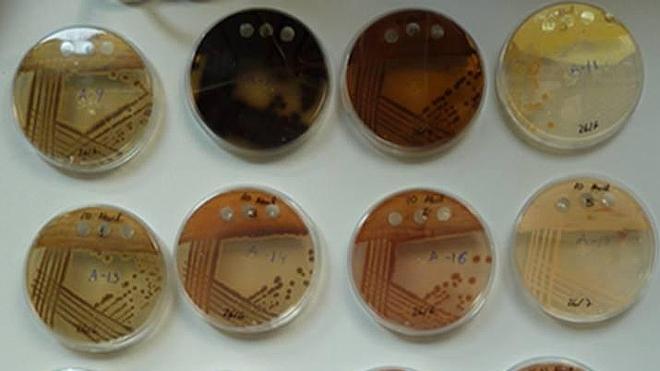
Lluvia de bacterias 'saludables'

20 nov 2015 01:06
Secciones
Servicios
- Obituarios
- Hemeroteca digital
- Mascotas en Asturias
- De boda en Asturias
- El Club
- Result. y clasificaciones
- El tiempo en Asturias
- Enlace con la Junta
- Horóscopo diario
- Farmacias de Asturias
- Guía de TV
- Asturianos por el mundo
- De tiendas
- Oferplan
- Sorteos y loterías
- Especiales EL COMERCIO
- Coches
- Empleo
- Guía Médica de Asturias
- Creando valor
Destacamos